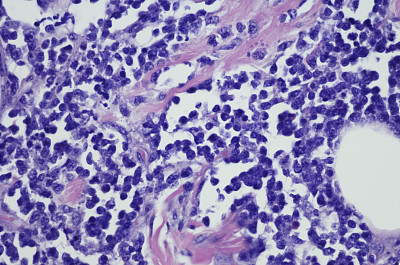

显微镜载玻片

请先登录后再下载
58明星,显微镜载玻片,实验室,医学研究,科学,显微镜,科学实验,病原,传染病,药,化学,生物学,研究,化学课,外科手套,埃博拉病毒,科学家,技术员,护手套,健康保健,人的手,瘟疫,试管,保护工作服,检查,材料,放置,大特写,生病,手术,特写,观看,人体,影棚拍摄,在下面,液体,看,摄影,拿着,操作,职业,水平画幅,布置,4K分辨率,图像